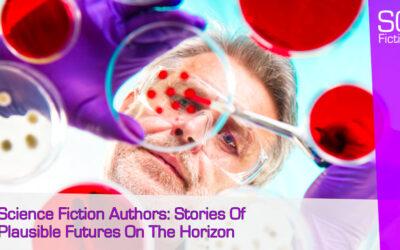

Creative Writing Blog Categories
Creative Writing Blog
Welcome to the creative writing blog of Belfast fiction author, Scott Gilmore. Scott is the UK’s top creative writing blogger, and this page gives practical advice for writers of all ages and experience levels.
Here you will find articles that include:
- Creative Writing Tips & Advice,
- Book Marketing & Promotion Pointers and
- ‘Type Cast’ Young Author interviews.
Composing a creative writing blog article every week, Scott aims to create content that is of use to writers of all abilities and skill levels. He believes it is essential to share his experiences working as a fiction author and professional SEO copywriter. The blog content is composed in the hope that others can implement elements of blogging, website development, and fiction writing tips to reach new readers.
Whether you are just starting as a writer or an experienced author with multiple fiction books under your belt, there will be a blog article that speaks to you. Having an understanding of the publication and promotional process is vital, especially as many writers choose to be independently or self-published. By using the search function, you can browse the many articles to see if one of Scott’s articles can help.
After writing his debut novels, Inside Iris and Anna’s Awakening, Scott was determined to assist other aspiring authors on their writing journey. As an active member of the online writing community, Scott loves to hear from fellow writers with suggestions for blog content. If you have any ideas for future articles, contact Scott with your suggestion via email.
Creative Writing Blog Sharing & Collaborations
When sharing an SG Fiction blog article, simply read a blog, share it on social media, and comment in the section at the bottom to start a conversation. Scott loves to read comments from contributors and replies as regularly as he can.
Blog collaborations are an excellent way to forge relationships within the writing community as well as developing website SEO. For those bloggers and writers with websites of their own, Scott actively collaborates with content creators to generate blog topics on the SG Fiction website. If you are a writer and would be interested in a blog collaboration, contact Scott via email or social media today.
Belfast Today: Use Your Hometown To Inspire Your Next Book
Belfast today is a city that is far removed from the one I grew up in during the '90s. Here's how you can use your hometown to plan your next book. In this Belfast Today article, you will find information on the following areas: How our hometown’s past can...
Science Fiction Authors: Stories Of Plausible Futures On The Horizon
Science fiction authors are incredibly popular writers in literature. By composing stories of plausible futures on the horizon, can they be considered entertainment or warnings for us in the present day? In this Science Fiction Authors article, you will find...
Recording Audiobooks: Tips To Create An Audible Recording Of Your Book
Recording audiobooks can be a daunting task for any writer. However, it needn't be that way. Use my 7 tips to create an audible recording of your book. In this Recording Audiobooks article, you will find information on the following areas: Why starting with...
Male Characters: The Real-Life Issues Forgotten About With Men In Fiction
Male characters have been relegated in entertainment recently. In real-life, men face many issues that can be forgotten about in fiction. Here are five examples of traits men face that could be further represented in fiction. In this Male Characters article, you...
The Elevator Pitch: Selling Yourself & Your Novels When It Really Matters
'The elevator pitch' is often overused. Yet, knowing what makes your writing unique is vital. Learn to sell yourself & your novels when it really matters. In this Elevator Pitch article, you will find information on the following areas: How an elevator pitch can...
Author Branding: How To Write Your Own Story & Connect With Readers
Author branding is something all writers, authors & poets need to consider in 2020 & beyond. Here are 5 tips to write your own story & connect with readers. In this Author Branding article, you will find information on the following areas: Why...